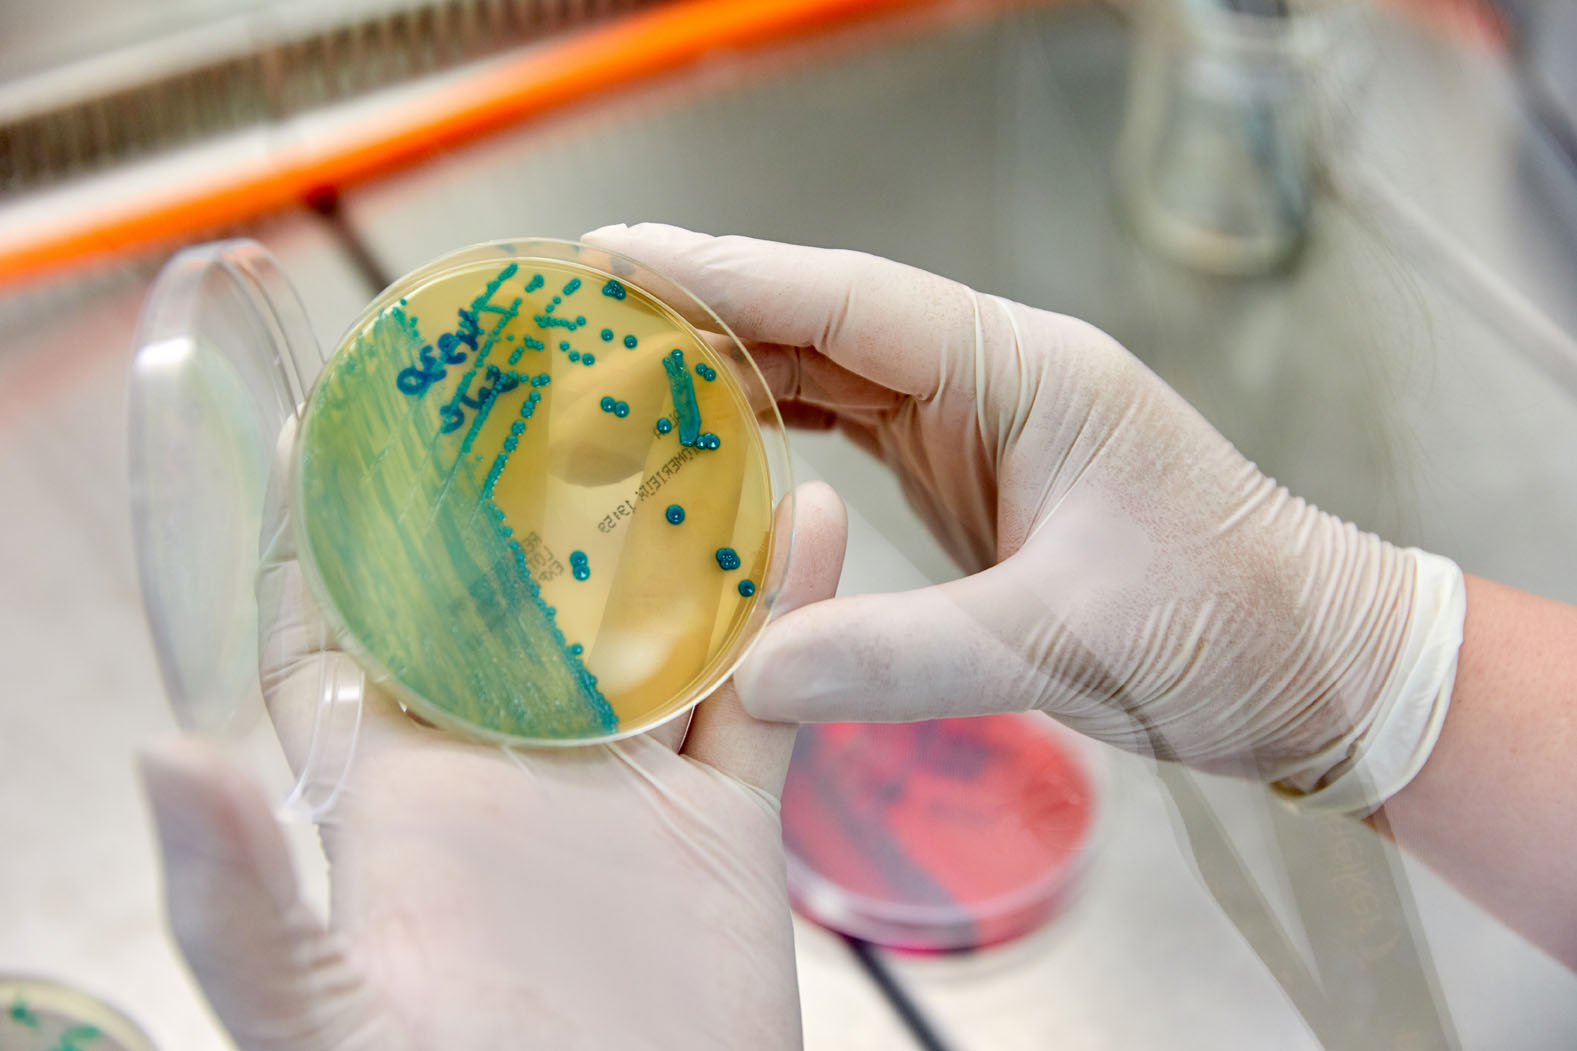

NEW
Boosting research into animal health and biosecurity with renovated facilities
12 November 2025
- The expansion of the Level 3 Biological Containment Facilities at NEIKER’s headquarters in Derio includes five independent laboratories and new experimentation areas adapted to the most demanding animal welfare standards.
NEIKER’s research capacity and biosafety have been reinforced with the comprehensive renovation of the Biosafety Level 3 facility (BSL3), also known as the P3 laboratory, which allows us to work more safely and efficiently in the study of high-risk pathogens that cause diseases such as tuberculosis and avian influenza.
Since 2002, in response to the health alert caused by ‘mad cow disease’, we have had a laboratory of this type at our headquarters in Derio. With an investment of €5 million, financed by the State Research Agency and, to a greater extent, by the Basque Government’s Department of Food, Rural Development, Agriculture and Fisheries, we have carried out a complete refurbishment that expands its surface area to 900 square metres and comprehensively modernises the safety, biocontainment and energy efficiency systems, placing our facilities among the most advanced in Europe in their category.
A full reorganisation
The renovation involved a complete reorganisation of the workspaces, with the creation of five independent laboratories and new experimentation areas adapted to current regulations and the highest standards of animal welfare. Specifically, it has an animal facility with four rooms for small animals, four boxes for large animals, a necropsy room and various common areas that facilitate research and the safe handling of pathogens.
In addition, the air conditioning and air filtration systems have been upgraded with high-efficiency HEPA filters, and a new effluent treatment plant and incinerator have been installed, both housed in the biocontainment area, for the safe disposal of waste, ensuring that nothing leaves the laboratory without proper treatment.
Among the main improvements, the redundancy of critical equipment, such as filtration systems and double-door autoclaves, also stands out, ensuring continuity of operations and maintaining maximum safety conditions at all times. Likewise, the incorporation of a geothermal system used both for air conditioning and for heating domestic water reduces energy consumption and moves towards a more sustainable operating model.
These technological improvements are complemented by a highly specialised team, trained and experienced in handling high-risk pathogens and complying with the most demanding biosafety protocols. ‘Their knowledge and technical skills are essential to ensure that research is carried out safely, efficiently and with the utmost scientific rigour,’ explains Joseba Garrido, head of NEIKER’s Animal Health Department.
European benchmark
With this renovation, the centre has consolidated its position as a European benchmark in animal health and biosecurity research, placing itself at the forefront of the study, diagnosis and control of diseases that affect both animals and public health.
Furthermore, thanks to these state-of-the-art facilities, the research team can more effectively address current and future challenges in animal health, in a global context marked by the emergence and re-emergence of infectious diseases.
All this work is carried out under the One Health approach, which recognises the interdependence between animal, human and environmental health, guiding the centre’s work towards a safer, more sustainable and resilient agri-food system.
In short
Facility for working more safely and efficiently in the study of high-risk pathogens.
900 square metres of biocontained area in Derio divided into:
- five laboratories
- animal facility with four rooms for small animals
- four boxes for large animals
- necropsy room
- common areas.